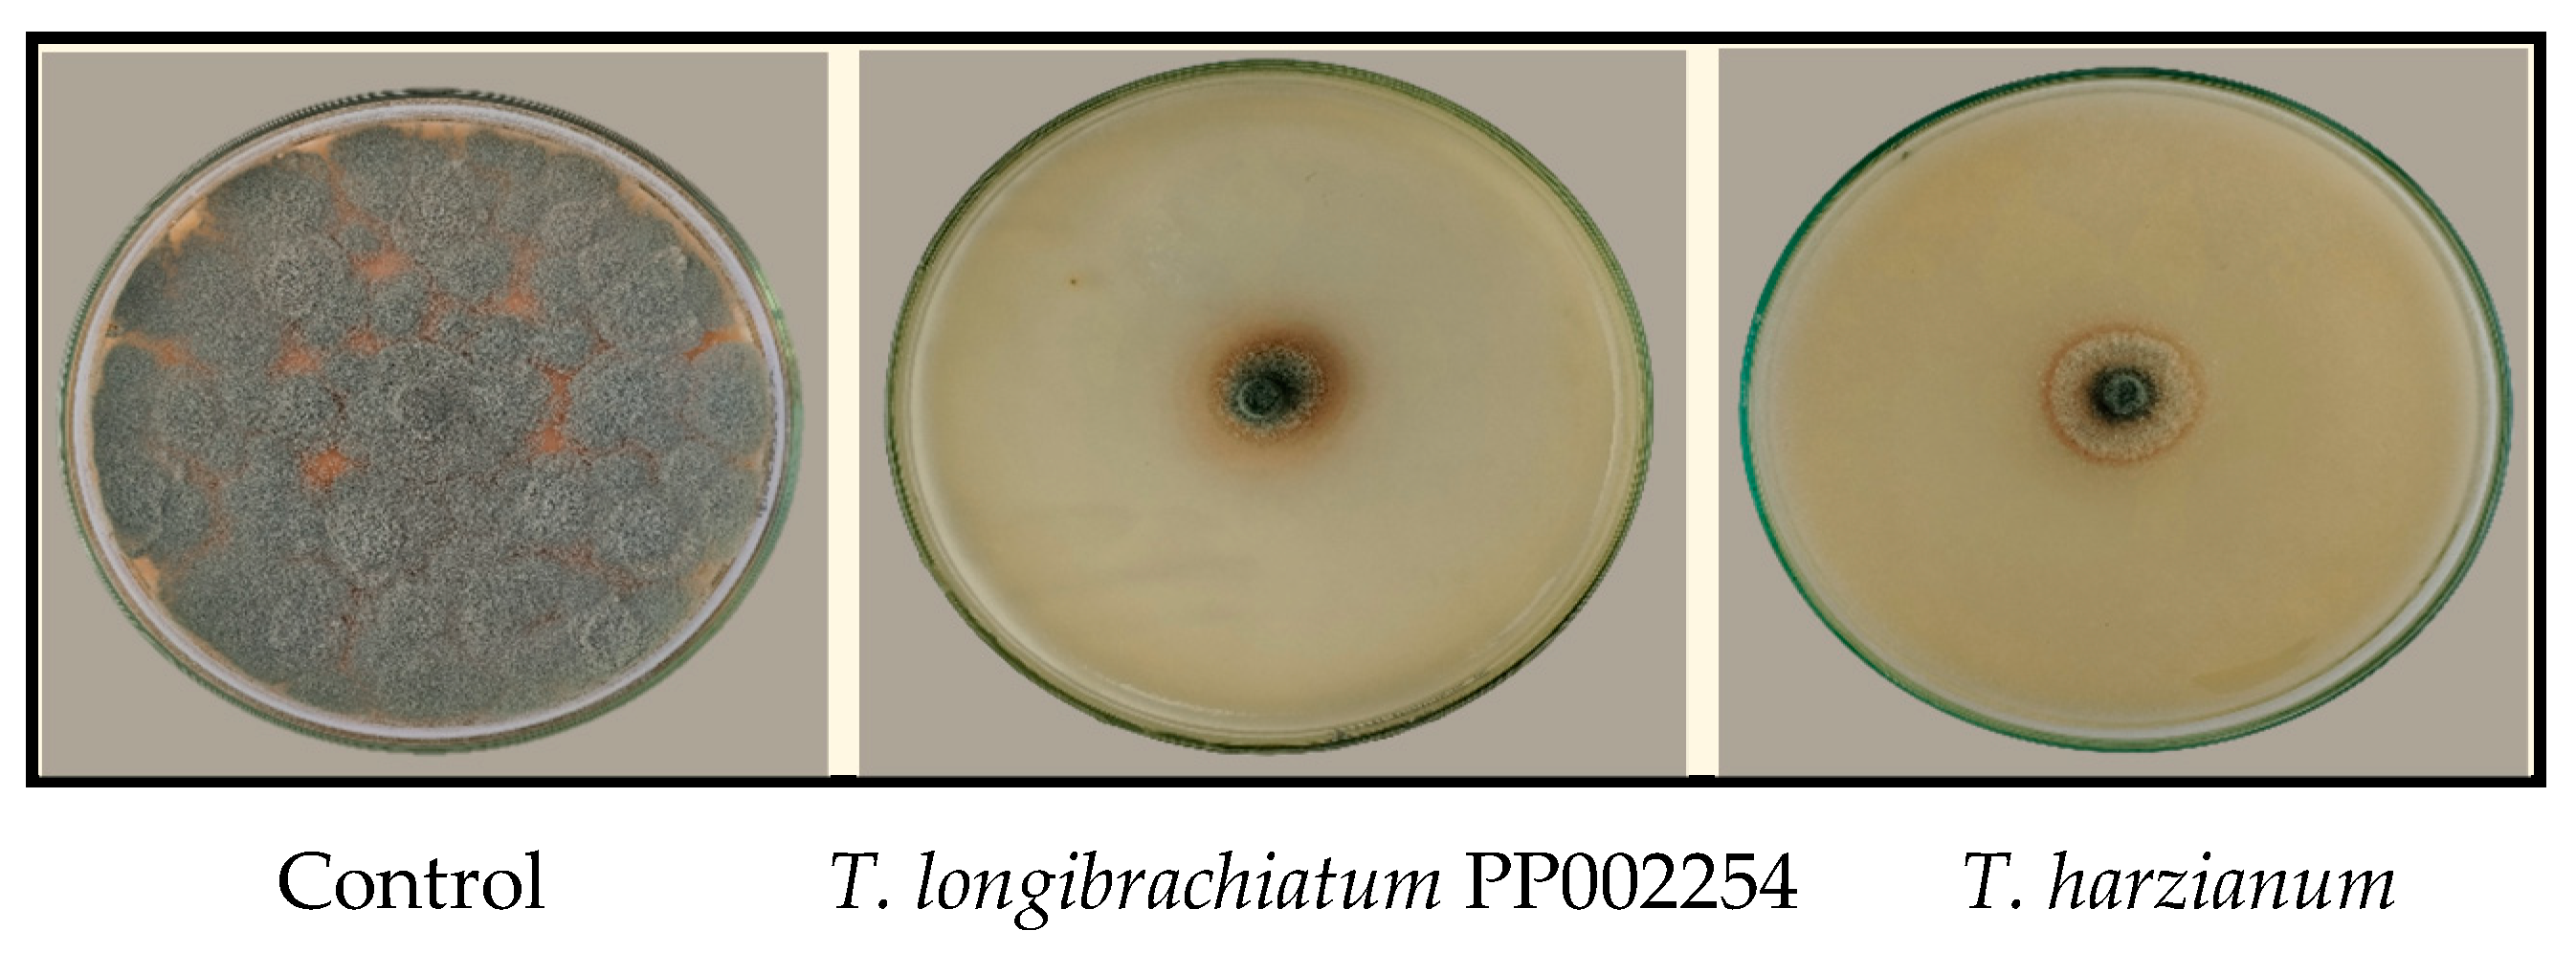
Horticulturae 10 01076 g003

New Trichoderma Strains Suppress Blue Mold in Oranges by Damaging the Cell Membrane of Penicillium italicum and Enhancing Both Enzymatic and Non-Enzymatic Defense Mechanisms in Orange Fruits
Abstract
1. Introduction
2. Materials and Methods
2.1. Isolation and Identification of P. italicum
2.2. Isolation of Trichoderma Isolates
2.3. Dual Culture Assay
2.4. Molecular Identification of Trichoderma Isolates
2.5. Preparation and Evaluation of Trichoderma Culture Filtrate
2.6. Microscopic Examination of P. italicum Hyphae Treated with Culture Filtrate of T. longibrachiatum PP002254 and T. harzianum PP002272 by Scanning Electron Microscope
2.7. In Vivo Treatments
2.8. Effect of T. longibrachiatum PP002254 and T. harzianum PP002272 Culture Filtrate on Physiological and Biochemical Changes in Orange Fruits
2.8.1. The Activity of Defense-Related Enzymes
2.8.2. Total Soluble Phenolic Compounds
2.8.3. Total Soluble Flavonoid Compounds
2.8.4. Assessment of Malondialdehyde as an Indication of Lipid Peroxidation
2.9. Statistical Analysis
3. Results
3.1. Morphological and Molecular Identification of T. longibrachiatum PP002254 and T. harzianum PP002272 Isolates
3.2. Dual Culture Assay: Antifungal Activity of Trichoderma Isolates
3.3. Culture Filtrate of T. longibrachiatum PP002254 and T. harzianum PP002272 and Its Effect on P. italicum Growth
3.4. Scanning Electron Microscopy (SEM) of P. italicum Hyphae Treated with Culture Filtrate
3.5. In Vivo Biocontrol Activity of T. longibrachiatum PP002254 and T. harzianum PP002272
3.6. Impact of T. longibrachiatum PP002254 and T. harzianum PP002272 Culture Filtrates on Enzyme Activity in Orange Fruits
3.7. Non-Enzymatic Antioxidants: Total Soluble Phenolics and Flavonoids
3.8. Reduction of Lipid Peroxidation in Orange Fruits
4. Discussion
5. Conclusions
Author Contributions
Funding
Data Availability Statement
Conflicts of Interest
References
- Lu, X.; Zhao, C.; Shi, H.; Liao, Y.; Xu, F.; Du, H.; Xiao, H.; Zheng, J. Nutrients and Bioactives in Citrus Fruits: Different Citrus Varieties, Fruit Parts, and Growth Stages. Crit. Rev. Food Sci. Nutr. 2023, 63, 2018–2041. [Google Scholar] [CrossRef] [PubMed]
- Wang, Z.; Sui, Y.; Li, J.; Tian, X.; Wang, Q. Biological Control of Postharvest Fungal Decays in Citrus: A Review. Crit. Rev. Food Sci. Nutr. 2022, 62, 861–870. [Google Scholar] [CrossRef]
- Bhatta, U.K. Alternative Management Approaches of Citrus Diseases Caused by Penicillium digitatum (Green Mold) and Penicillium italicum (Blue Mold). Front. Plant Sci. 2022, 12, 833328. [Google Scholar] [CrossRef]
- Ibrahim, O.H.M.; Abo-Elyousr, K.A.M. Potential Antifungal Activity of Various Botanical Extracts against the Causal Pathogen of the Blue Mold of Citrus Fruits. J. Plant Pathol. 2023, 105, 527–538. [Google Scholar] [CrossRef]
- Lima, P.G.; Freitas, C.D.T.; Oliveira, J.T.A.; Neto, N.A.S.; Amaral, J.L.; Silva, A.F.B.; Sousa, J.S.; Franco, O.L.; Souza, P.F.N. Synthetic Antimicrobial Peptides Control Penicillium digitatum Infection in Orange Fruits. Food Res. Int. 2021, 147, 110582. [Google Scholar] [CrossRef]
- Papoutsis, K.; Mathioudakis, M.M.; Hasperué, J.H.; Ziogas, V. Non-Chemical Treatments for Preventing the Postharvest Fungal Rotting of Citrus Caused by Penicillium digitatum (Green Mold) and Penicillium italicum (Blue Mold). Trends Food Sci. Technol. 2019, 86, 479–491. [Google Scholar] [CrossRef]
- Yao, Y.; Li, Y.; Zhao, L.; Li, S.; Zhou, Z. Citrus Lemon (Citrus limon (L.) Burm. f. Cv. Eureka) Essential Oil Controls Blue Mold in Citrus by Damaging the Cell Membrane of Penicillium italicum. LWT 2023, 188, 115456. [Google Scholar] [CrossRef]
- Elsherbiny, E.A.; Taher, M.A.; Abd El-Aziz, M.H.; Mohamed, S.Y. Action Mechanisms and Biocontrol of Purpureocillium lilacinum against Green Mould Caused by Penicillium digitatum in Orange Fruit. J. Appl. Microbiol. 2021, 131, 1378–1390. [Google Scholar] [CrossRef]
- Wang, F.; Xiao, J.; Zhang, Y.; Li, R.; Liu, L.; Deng, J. Biocontrol Ability and Action Mechanism of Bacillus halotolerans against Botrytis cinerea Causing Grey Mould in Postharvest Strawberry Fruit. Postharvest Biol. Technol. 2021, 174, 111456. [Google Scholar] [CrossRef]
- Zhang, J.; He, L.; Guo, C.; Liu, Z.; Kaliaperumal, K.; Zhong, B.; Jiang, Y. Evaluation of Aspergillus aculeatus GC-09 for the Biological Control of Citrus Blue Mold Caused by Penicillium italicum. Fungal Biol. 2022, 126, 201–212. [Google Scholar] [CrossRef] [PubMed]
- da Costa, A.C.; de Miranda, R.F.; Costa, F.A.; Ulhoa, C.J. Potential of Trichoderma piluliferum as a Biocontrol Agent of Colletotrichum musae in Banana Fruits. Biocatal. Agric. Biotechnol. 2021, 34, 102028. [Google Scholar] [CrossRef]
- Zin, N.A.; Badaluddin, N.A. Biological Functions of Trichoderma Spp. for Agriculture Applications. Ann. Agric. Sci. 2020, 65, 168–178. [Google Scholar] [CrossRef]
- Cummings, N.J.; Ambrose, A.; Braithwaite, M.; Bissett, J.; Roslan, H.A.; Abdullah, J.; Stewart, A.; Agbayani, F.V.; Steyaert, J.; Hill, R.A. Diversity of Root-Endophytic Trichoderma from Malaysian Borneo. Mycol. Prog. 2016, 15, 50. [Google Scholar] [CrossRef]
- Geng, L.; Fu, Y.; Peng, X.; Yang, Z.; Zhang, M.; Song, Z.; Guo, N.; Chen, S.; Chen, J.; Bai, B.; et al. Biocontrol Potential of Trichoderma harzianum against Botrytis cinerea in Tomato Plants. Biol. Control 2022, 174, 105019. [Google Scholar] [CrossRef]
- Benitez, T.; Rincón, A.M.; Limón, M.C.; Codon, A.C. Biocontrol Mechanisms of Trichoderma Strains. Int. Microbiol. 2004, 7, 249–260. [Google Scholar] [PubMed]
- Ferreira, F.V.; Musumeci, M.A. Trichoderma as Biological Control Agent: Scope and Prospects to Improve Efficacy. World J. Microbiol. Biotechnol. 2021, 37, 90. [Google Scholar] [CrossRef]
- Zhang, H.; Kong, N.; Liu, B.; Yang, Y.; Li, C.; Qi, J.; Ma, Y.; Ji, S.; Liu, Z. Biocontrol Potential of Trichoderma harzianum CGMCC20739 (Tha739) against Postharvest Bitter Rot of Apples. Microbiol. Res. 2022, 265, 127182. [Google Scholar] [CrossRef]
- Hu, Y.J.; Yang, H.M.; Jin, J.; Yan, H.H.; Wang, J.P.; Zhang, R.Q. Synergistic Activity of Antagonistic Trichoderma Spp. and Rhizoctonia solani Increases Disease Severity on Strawberry Petioles. Eur. J. Plant Pathol. 2022, 164, 375–389. [Google Scholar] [CrossRef]
- Abdel-lateif, K.S. Trichoderma as Biological Control Weapon against Soil Borne Plant Pathogens. Afr. J. Biotechnol. 2017, 16, 2299–2306. [Google Scholar]
- Rahman, M.; Sabir, A.A.; Mukta, J.A.; Khan, M.A.; Mohi-Ud-Din, M.; Miah, M.G.; Rahman, M.; Islam, M.T. Plant Probiotic Bacteria Bacillus and Paraburkholderia Improve Growth, Yield and Content of Antioxidants in Strawberry Fruit. Sci. Rep. 2018, 8, 2504. [Google Scholar] [CrossRef]
- Yousif, A.A.; Hassan, W.A. Molecular Identification of Postharvest Moldy Core Pathogens on Apple and Application of Biocontrol Products of Essential Oils (EOs) and Trichoderma harzianum. Basrah J. Agric. Sci. 2023, 36, 1–15. [Google Scholar] [CrossRef]
- Alvindia, D.G. The Antagonistic Action of Trichoderma harzianum Strain DGA01 against Anthracnose-Causing Pathogen in Mango Cv. Carabao. Biocontrol Sci. Technol. 2018, 28, 591–602. [Google Scholar] [CrossRef]
- Devi, A.N.; Arumugam, T. Studies on the Shelf Life and Quality of Rasthali Banana as Affected by Postharvest Treatments. Orissa J. Hortic. 2005, 33, 3–6. [Google Scholar]
- Batta, Y.A. Control of Postharvest Diseases of Fruit with an Invert Emulsion Formulation of Trichoderma harzianum Rifai. Postharvest Biol. Technol. 2007, 43, 143–150. [Google Scholar] [CrossRef]
- Ferreira, F.V.; Herrmann-Andrade, A.M.; Calabrese, C.D.; Bello, F.; Vázquez, D.; Musumeci, M.A. Effectiveness of Trichoderma Strains Isolated from the Rhizosphere of Citrus Tree to Control Alternaria Alternata, Colletotrichum Gloeosporioides and Penicillium digitatum A21 Resistant to Pyrimethanil in Post-Harvest Oranges (Citrus sinensis L. (Osbeck)). J. Appl. Microbiol. 2020, 129, 712–727. [Google Scholar] [CrossRef]
- Valenzuela, N.L.; Angel, D.N.; Ortiz, D.T.; Rosas, R.A.; García, C.F.O.; Santos, M.O. Biological Control of Anthracnose by Postharvest Application of Trichoderma spp. on Maradol Papaya Fruit. Biol. Control 2015, 91, 88–93. [Google Scholar] [CrossRef]
- Kim, S.H.; Lee, Y.; Balaraju, K.; Jeon, Y. Evaluation of Trichoderma Atroviride and Trichoderma longibrachiatum as Biocontrol Agents in Controlling Red Pepper Anthracnose in Korea. Front. Plant Sci. 2023, 14, 1201875. [Google Scholar] [CrossRef]
- Nurbailis, N.; Djamaan, A.; Rahma, H.; Liswarni, Y. Potential of Culture Filtrate from Trichoderma spp. as Biofungicide to Colletotrichum Gloeosporioides Causing Anthracnose Disease in Chili. Biodiversitas J. Biol. Divers. 2019, 20, 2915–2920. [Google Scholar] [CrossRef]
- Manzar, N.; Singh, Y.; Kashyap, A.S.; Sahu, P.K.; Rajawat, M.V.S.; Bhowmik, A.; Sharma, P.K.; Saxena, A.K. Biocontrol Potential of Native Trichoderma spp. against Anthracnose of Great Millet (Sorghum bicolour L.) from Tarai and Hill Regions of India. Biol. Control 2021, 152, 104474. [Google Scholar] [CrossRef]
- Nehra, S.; Gothwal, R.K.; Dhingra, S.; Varshney, A.K.; Solanki, P.S.; Meena, P.; Trivedi, P.C.; Ghosh, P. Mechanism of Antagonism: Hyperparasitism and Antibiosis. In Microbial Biocontrol: Sustainable Agriculture and Phytopathogen Management; Springer: Cham, Switzerland, 2022; pp. 257–277. [Google Scholar]
- Houbraken, J.; Kocsubé, S.; Visagie, C.M.; Yilmaz, N.; Wang, X.-C.; Meijer, M.; Kraak, B.; Hubka, V.; Bensch, K.; Samson, R.A.; et al. Classification of Aspergillus, Penicillium, Talaromyces and Related Genera (Eurotiales): An Overview of Families, Genera, Subgenera, Sections, Series and Species. Stud. Mycol. 2020, 95, 5–169. [Google Scholar] [CrossRef]
- Debbi, A.; Boureghda, H.; Monte, E.; Hermosa, R. Distribution and Genetic Variability of Fusarium oxysporum Associated with Tomato Diseases in Algeria and a Biocontrol Strategy with Indigenous Trichoderma spp. Front. Microbiol. 2018, 9, 342493. [Google Scholar] [CrossRef] [PubMed]
- Shaigan, S.; Seraji, A.; Moghaddam, S.A. Identification and Investigation on Antagonistic Effect of Trichoderma spp. on Tea Seedlings White Foot and Root Rot (Sclerotium rolfsii Sacc.) in Vitro Condition. Pak. J. Biol. Sci. PJBS 2008, 11, 2346–2350. [Google Scholar] [CrossRef] [PubMed]
- Pimentel, M.F.; Arnão, E.; Warner, A.J.; Subedi, A.; Rocha, L.F.; Srour, A.; Bond, J.P.; Fakhoury, A.M. Trichoderma Isolates Inhibit Fusarium virguliforme Growth, Reduce Root Rot, and Induce Defense-Related Genes on Soybean Seedlings. Plant Dis. 2020, 104, 1949–1959. [Google Scholar] [CrossRef] [PubMed]
- El-Nagar, A.; Elzaawely, A.A.; Xuan, T.D.; Gaber, M.; El-Wakeil, N.; El-Sayed, Y.; Nehela, Y. Metal Complexation of Bis-Chalcone Derivatives Enhances Their Efficacy against Fusarium Wilt Disease, Caused by Fusarium equiseti, via Induction of Antioxidant Defense Machinery. Plants 2022, 11, 2418. [Google Scholar] [CrossRef] [PubMed]
- Osman, H.E.M.; Nehela, Y.; Elzaawely, A.A.; El-Morsy, M.H.; El-Nagar, A. Two Bacterial Bioagents Boost Onion Response to Stromatinia cepivora and Promote Growth and Yield via Enhancing the Antioxidant Defense System and Auxin Production. Horticulturae 2023, 9, 780. [Google Scholar] [CrossRef]
- Abdel-Aziz, M.M.; Emam, T.M.; Elsherbiny, E.A. Bioactivity of Magnesium Oxide Nanoparticles Synthesized from Cell Filtrate of Endobacterium Burkholderia rinojensis against Fusarium oxysporum. Mater. Sci. Eng. C 2020, 109, 110617. [Google Scholar] [CrossRef]
- El-Nagar, A.; Elzaawely, A.A.; El-Zahaby, H.M.; Xuan, T.D.; Khanh, T.D.; Gaber, M.; El-Wakeil, N.; El-Sayed, Y.; Nehela, Y. Benzimidazole Derivatives Suppress Fusarium Wilt Disease via Interaction with ERG6 of Fusarium equiseti and Activation of the Antioxidant Defense System of Pepper Plants. J. Fungi 2023, 9, 244. [Google Scholar] [CrossRef]
- Aebi, H. Catalase in Vitro. Methods Enzymol. 1984, 105, 121–126. [Google Scholar]
- Harrach, B.D.; Fodor, J.; Pogány, M.; Preuss, J.; Barna, B. Antioxidant, Ethylene and Membrane Leakage Responses to Powdery Mildew Infection of near-Isogenic Barley Lines with Various Types of Resistance. Eur. J. Plant Pathol. 2008, 121, 21–33. [Google Scholar] [CrossRef]
- Malik, C.P.; Singh, M.B. Plant Enzymology and Histo-Enzymology; Kalyani Publishers: New Delhi, India, 1980. [Google Scholar]
- Zhang, Z.; Yang, D.; Yang, B.; Gao, Z.; Li, M.; Jiang, Y.; Hu, M. β-Aminobutyric Acid Induces Resistance of Mango Fruit to Postharvest Anthracnose Caused by Colletotrichum gloeosporioides and Enhances Activity of Fruit Defense Mechanisms. Sci. Hortic. 2013, 160, 78–84. [Google Scholar] [CrossRef]
- Assis, J.S.; Maldonado, R.; Muñoz, T.; Escribano, M.I.; Merodio, C. Effect of High Carbon Dioxide Concentration on PAL Activity and Phenolic Contents in Ripening Cherimoya Fruit. Postharvest Biol. Technol. 2001, 23, 33–39. [Google Scholar] [CrossRef]
- Kähkönen, M.P.; Hopia, A.I.; Vuorela, H.J.; Rauha, J.P.; Pihlaja, K.; Kujala, T.S.; Heinonen, M. Antioxidant Activity of Plant Extracts Containing Phenolic Compounds. J. Agric. Food Chem. 1999, 47, 3954–3962. [Google Scholar] [CrossRef] [PubMed]
- Djeridane, A.; Yousfi, M.; Nadjemi, B.; Boutassouna, D.; Stocker, P.; Vidal, N. Antioxidant Activity of Some Algerian Medicinal Plants Extracts Containing Phenolic Compounds. Food Chem. 2006, 97, 654–660. [Google Scholar] [CrossRef]
- Du, Z.; Bramlage, W.J. Modified Thiobarbituric Acid Assay for Measuring Lipid Oxidation in Sugar-Rich Plant Tissue Extracts. J. Agric. Food Chem. 1992, 40, 1566–1570. [Google Scholar] [CrossRef]
- Zacarias, L.; Cronje, P.J.R.; Palou, L. Postharvest Technology of Citrus Fruits. In The Genus Citrus; Elsevier: Amsterdam, The Netherlands, 2020; pp. 421–446. [Google Scholar]
- Li, J.; Li, H.; Ji, S.; Chen, T.; Tian, S.; Qin, G. Enhancement of Biocontrol Efficacy of Cryptococcus laurentii by Cinnamic Acid against Penicillium italicum in Citrus Fruit. Postharvest Biol. Technol. 2019, 149, 42–49. [Google Scholar] [CrossRef]
- Youssef, K.; Hussien, A. Electrolysed Water and Salt Solutions Can Reduce Green and Blue Molds While Maintain the Quality Properties of Valencialate Oranges. Postharvest Biol. Technol. 2020, 159, 111025. [Google Scholar] [CrossRef]
- Chen, C.; Cai, N.; Chen, J.; Wan, C. Clove Essential Oil as an Alternative Approach to Control Postharvest Blue Mold Caused by Penicillium italicum in Citrus Fruit. Biomolecules 2019, 9, 197. [Google Scholar] [CrossRef]
- De Sousa, M.A.; Granada, C.E. Biological Control of Pre- and Post-Harvest Microbial Diseases in Citrus by Using Beneficial Microorganisms. Biocontrol 2023, 68, 75–86. [Google Scholar] [CrossRef]
- Manzar, N.; Kashyap, A.S.; Goutam, R.S.; Rajawat, M.V.S.; Sharma, P.K.; Sharma, S.K.; Singh, H.V. Trichoderma: Advent of Versatile Biocontrol Agent, Its Secrets and Insights into Mechanism of Biocontrol Potential. Sustainability 2022, 14, 12786. [Google Scholar] [CrossRef]
- Mukherjee, A.K.; Sampath Kumar, A.; Kranthi, S.; Mukherjee, P.K. Biocontrol Potential of Three Novel Trichoderma Strains: Isolation, Evaluation and Formulation. 3 Biotech 2014, 4, 275–281. [Google Scholar] [CrossRef]
- Larran, S.; Santamarina Siurana, M.P.; Roselló Caselles, J.; Simón, M.R.; Perelló, A. In Vitro Antagonistic Activity of Trichoderma harzianum against Fusarium Sudanense Causing Seedling Blight and Seed Rot on Wheat. ACS Omega 2020, 5, 23276–23283. [Google Scholar] [CrossRef] [PubMed]
- Sridharan, A.P.; Sugitha, T.; Karthikeyan, G.; Nakkeeran, S.; Sivakumar, U. Metabolites of Trichoderma longibrachiatum EF5 Inhibits Soil Borne Pathogen, Macrophomina Phaseolina by Triggering Amino Sugar Metabolism. Microb. Pathog. 2021, 150, 104714. [Google Scholar] [CrossRef]
- Sridharan, A.P.; Thankappan, S.; Karthikeyan, G.; Uthandi, S. Comprehensive Profiling of the VOCs of Trichoderma longibrachiatum EF5 While Interacting with Sclerotium rolfsii and Macrophomina phaseolina. Microbiol. Res. 2020, 236, 126436. [Google Scholar] [CrossRef]
- Mahmoud, G.A.-E.; Abdel-Sater, M.A.; Al-Amery, E.; Hussein, N.A. Controlling Alternaria cerealis MT808477 Tomato Phytopathogen by Trichoderma harzianum and Tracking the Plant Physiological Changes. Plants 2021, 10, 1846. [Google Scholar] [CrossRef] [PubMed]
- Paul, N.C.; Park, S.; Liu, H.; Lee, J.G.; Han, G.H.; Kim, H.; Sang, H. Fungi Associated with Postharvest Diseases of Sweet Potato Storage Roots and in Vitro Antagonistic Assay of Trichoderma harzianum against the Diseases. J. Fungi 2021, 7, 927. [Google Scholar] [CrossRef]
- Cherkupally, R.; Amballa, H.; Reddy, B.N. In Vitro Antagonistic Activity of Trichoderma and Penicillium Species against Macrophomina phaseolina (Tassi) Goid. Ann. Biol. Res. 2016, 7, 34–38. [Google Scholar]
- Ngo, M.T.; Van Nguyen, M.; Han, J.W.; Park, M.S.; Kim, H.; Choi, G.J. In Vitro and in Vivo Antifungal Activity of Sorbicillinoids Produced by Trichoderma longibrachiatum. J. Fungi 2021, 7, 428. [Google Scholar] [CrossRef] [PubMed]
- Rubio, M.B.; Pardal, A.J.; Cardoza, R.E.; Gutiérrez, S.; Monte, E.; Hermosa, R. Involvement of the Transcriptional Coactivator ThMBF1 in the Biocontrol Activity of Trichoderma harzianum. Front. Microbiol. 2017, 8, 2273. [Google Scholar] [CrossRef]
- Deng, J.-J.; Huang, W.-Q.; Li, Z.-W.; Lu, D.-L.; Zhang, Y.; Luo, X. Biocontrol Activity of Recombinant Aspartic Protease from Trichoderma harzianum against Pathogenic Fungi. Enzym. Microb. Technol. 2018, 112, 35–42. [Google Scholar] [CrossRef]
- Ghorbanpour, M.; Omidvari, M.; Abbaszadeh-Dahaji, P.; Omidvar, R.; Kariman, K. Mechanisms Underlying the Protective Effects of Beneficial Fungi against Plant Diseases. Biol. Control 2018, 117, 147–157. [Google Scholar] [CrossRef]
- Maruyama, C.R.; Bilesky-José, N.; de Lima, R.; Fraceto, L.F. Encapsulation of Trichoderma harzianum Preserves Enzymatic Activity and Enhances the Potential for Biological Control. Front. Bioeng. Biotechnol. 2020, 8, 225. [Google Scholar] [CrossRef] [PubMed]
- Guzmán-Guzmán, P.; Kumar, A.; de Los Santos-Villalobos, S.; Parra-Cota, F.I.; Orozco-Mosqueda, M.d.C.; Fadiji, A.E.; Hyder, S.; Babalola, O.O.; Santoyo, G. Trichoderma Species: Our Best Fungal Allies in the Biocontrol of Plant Diseases A Review. Plants 2023, 12, 432. [Google Scholar] [CrossRef]
- Rahimi Tamandegani, P.; Marik, T.; Zafari, D.; Balázs, D.; Vágvölgyi, C.; Szekeres, A.; Kredics, L. Changes in Peptaibol Production of Trichoderma Species during in Vitro Antagonistic Interactions with Fungal Plant Pathogens. Biomolecules 2020, 10, 730. [Google Scholar] [CrossRef]
- Asad, S.A.; Tabassum, A.; Hameed, A.; Afzal, A.; Khan, S.A.; Ahmed, R.; Shahzad, M. Determination of Lytic Enzyme Activities of Indigenous Trichoderma Isolates from Pakistan. Braz. J. Microbiol. 2015, 46, 1053–1064. [Google Scholar] [CrossRef] [PubMed]
- Leylaie, S.; Zafari, D. Antiproliferative and Antimicrobial Activities of Secondary Metabolites and Phylogenetic Study of Endophytic Trichoderma Species From Vinca Plants. Front. Microbiol. 2018, 9, 1484. [Google Scholar] [CrossRef]
- Sharma, P.; Jha, A.B.; Dubey, R.S.; Pessarakli, M. Reactive Oxygen Species, Oxidative Damage, and Antioxidative Defense Mechanism in Plants under Stressful Conditions. J. Bot. 2012, 2012, 217037. [Google Scholar] [CrossRef]
- Thakral, V.; Sudhakaran, S.; Jadhav, H.; Mahakalkar, B.; Sehra, A.; Dhar, H.; Kumar, S.; Sonah, H.; Sharma, T.R.; Deshmukh, R. Unveiling Silicon-Mediated Cadmium Tolerance Mechanisms in Mungbean (Vigna radiata (L.) Wilczek): Integrative Insights from Gene Expression, Antioxidant Responses, and Metabolomics. J. Hazard. Mater. 2024, 474, 134671. [Google Scholar] [CrossRef]
- Song, Y.; Hu, C.; Xue, Y.; Gu, J.; He, J.; Ren, Y. 24-Epibrassinolide Enhances Mango Resistance to Colletotrichum gloeosporioides via Activating Multiple Defense Response. Sci. Hortic. 2022, 303, 111249. [Google Scholar] [CrossRef]
- Ren, Y.; Xue, Y.; Tian, D.; Zhang, L.; Xiao, G.; He, J. Improvement of Postharvest Anthracnose Resistance in Mango Fruit by Nitric Oxide and the Possible Mechanisms Involved. J. Agric. Food Chem. 2020, 68, 15460–15467. [Google Scholar] [CrossRef]
- Zhu, H.; Zhao, L.; Zhang, X.; Foku, J.M.; Li, J.; Hu, W.; Zhang, H. Efficacy of Yarrowia Lipolytica in the Biocontrol of Green Mold and Blue Mold in Citrus Reticulata and the Mechanisms Involved. Biol. Control 2019, 139, 104096. [Google Scholar] [CrossRef]
- Papoutsis, K.; Vuong, Q.V.; Tesoriero, L.; Pristijono, P.; Stathopoulos, C.E.; Gkountina, S.; Lidbetter, F.; Bowyer, M.C.; Scarlett, C.J.; Golding, J.B. Microwave Irradiation Enhances the In Vitro Antifungal Activity of Citrus by-Product Aqueous Extracts against Alternaria alternata. Int. J. Food Sci. Technol. 2018, 53, 1510–1517. [Google Scholar] [CrossRef]
- Imran, M.; Abo-Elyousr, K.A.M.; Mousa, M.A.A.; Saad, M.M. Use of Trichoderma Culture Filtrates as a Sustainable Approach to Mitigate Early Blight Disease of Tomato and Their Influence on Plant Biomarkers and Antioxidants Production. Front. Plant Sci. 2023, 14, 1192818. [Google Scholar] [CrossRef]
- Gulzar, S.; Manzoor, M.A.; Liaquat, F.; Shah, I.H.; Rehman, A.; Hameed, M.K.; Arif, S.; Zhou, X.; Zhang, Y. Effects of Melatonin and Trichoderma harzianum on Pak Choi Yield, Chlorophyll Contents and Antioxidant Defense System under Clubroot Disease. S. Afr. J. Bot. 2023, 158, 292–300. [Google Scholar] [CrossRef]
- Mohamed, B.F.; Sallam, N.M.; Alamri, S.A.M.; Abo-Elyousr, K.A.; Mostafa, Y.S.; Hashem, M. Approving the biocontrol method of potato wilt caused by Ralstonia solanacearum (Smith) using Enterobacter cloacae PS14 and Trichoderma asperellum T34. Egypt. J. Biol. Pest Control 2020, 30, 1–13. [Google Scholar] [CrossRef]
- Tamandegani, P.R.; Sharifnabi, B.; Massah, A.; Zahravi, M. Induced Reprogramming of Oxidative Stress Responses in Cucumber by Trichoderma asperellum (Iran 3062C) Enhances Defense against Cucumber Mosaic Virus. Biol. Control 2021, 164, 104779. [Google Scholar] [CrossRef]
- Pocurull, M.; Fullana, A.M.; Ferro, M.; Valero, P.; Escudero, N.; Saus, E.; Gabaldón, T.; Sorribas, F.J. Commercial Formulates of Trichoderma Induce Systemic Plant Resistance to Meloidogyne incognita in Tomato and the Effect Is Additive to That of the Mi-1.2 Resistance Gene. Front. Microbiol. 2020, 10, 3042. [Google Scholar] [CrossRef]
- Yao, X.; Guo, H.; Zhang, K.; Zhao, M.; Ruan, J.; Chen, J. Trichoderma and Its Role in Biological Control of Plant Fungal and Nematode Disease. Front. Microbiol. 2023, 14, 1160551. [Google Scholar] [CrossRef]
- Peer, W.A.; Murphy, A.S. Flavonoids as Signal Molecules: Targets of Flavonoid Action. In The Science of Flavonoids; Springer: New York, NY, USA, 2006; pp. 239–268. [Google Scholar]
- El-Tanany, M.M.; Hafez, M.A.; Ahmed, G.A.; Abd El-Mageed, M.H. Efficiency of Biotic and Abiotic Inducers for Controlling Tomato Early Blight Disease. Middle East J. Agric. Res. 2018, 7, 650–670. [Google Scholar]
- Morales, M.; Munné-Bosch, S. Malondialdehyde: Facts and Artifacts. Plant Physiol. 2019, 180, 1246–1250. [Google Scholar] [CrossRef]

| Treatment | Radial Mycelial Growth (cm) | % Inhibition |
|---|---|---|
| Control | 9.00 ± 0.00 a | 0.00 ± 0.00 b |
| T. longibrachiatum PP0022542 | 3.38 ± 0.18 b | 62.41 ± 2.04 a |
| T. harzianum PP002272 | 3.02 ± 0.23 b | 66.48 ± 2.53 a |
| Treatment | Radial Mycelial Growth (cm) | % Inhibition |
|---|---|---|
| Control | 9.00 ± 0.00 a | 0.00 ± 0.00 c |
| T. longibrachiatum PP0022542 | 2.05 ± 0.03 c | 77.22 ± 0.38 a |
| T. harzianum PP002272 | 2.55 ± 0.09 b | 66.48 ± 1.10 b |
| Treatment | Hours Post-Treatment (hpt) | |||
|---|---|---|---|---|
| 24 | 48 | 72 | 96 | |
| Control | 2.15 ± 0.036 b | 2.00 ± 0.026 b | 1.82 ± 0.036 c | 2.05 ± 0.039 b |
| T. longibrachiatum PP002254 | 0.98 ± 0.039 c | 1.32 ± 0.068 c | 9.60 ± 0.072 a | 5.72 ± 0.380 a |
| T. harzianum PP002272 | 3.17 ± 0.029 a | 3.77 ± 0.063 a | 6.96 ± 0.077 b | 5.26 ± 0.042 a |
| Treatment | Hours Post-Treatment (hpt) | |||
|---|---|---|---|---|
| 24 | 48 | 72 | 96 | |
| Control | 2.11 ± 0.081 a | 1.45 ± 0.087 c | 1.35 ± 0.049 c | 1.12 ± 0.011 b |
| T. longibrachiatum PP002254 | 1.64 ± 0.085 b | 1.85 ± 0.081 a | 2.69 ± 0.072 a | 1.51 ± 0.013 ab |
| T. harzianum PP002272 | 1.62 ± 0.090 b | 1.71 ± 0.0421 b | 2.36 ± 0.047 b | 1.68 ± 0.197 a |
| Treatment | Hours Post-Treatment (hpt) | |||
|---|---|---|---|---|
| 24 | 48 | 72 | 96 | |
| Control | 110.04 ± 7.11 a | 124.71 ± 2.85 a | 135.71 ± 4.95 a | 137.56 ± 3.65 a |
| T. longibrachiatum PP002254 | 52.94 ± 4.54 b | 62.61 ± 1.60 c | 79.67 ± 8.53 b | 100.77 ± 6.43 c |
| T. harzianum PP002272 | 70.46 ± 11.83 b | 98.63 ± 3.61 b | 110.62 ± 8.40 a | 120.43 ± 1.88 b |
Disclaimer/Publisher’s Note: The statements, opinions and data contained in all publications are solely those of the individual author(s) and contributor(s) and not of MDPI and/or the editor(s). MDPI and/or the editor(s) disclaim responsibility for any injury to people or property resulting from any ideas, methods, instructions or products referred to in the content. |
© 2024 by the authors. Licensee MDPI, Basel, Switzerland. This article is an open access article distributed under the terms and conditions of the Creative Commons Attribution (CC BY) license (https://creativecommons.org/licenses/by/4.0/).
Share and Cite
El-Nagar, A.; Mazrou, Y.S.A.; El-Fawy, M.M.; Abou-Shlell, M.K.; Seleim, M.A.A.; Makhlouf, A.H.; Hegazy, M.G.A. New Trichoderma Strains Suppress Blue Mold in Oranges by Damaging the Cell Membrane of Penicillium italicum and Enhancing Both Enzymatic and Non-Enzymatic Defense Mechanisms in Orange Fruits. Horticulturae 2024, 10, 1076. https://doi.org/10.3390/horticulturae10101076
El-Nagar A, Mazrou YSA, El-Fawy MM, Abou-Shlell MK, Seleim MAA, Makhlouf AH, Hegazy MGA. New Trichoderma Strains Suppress Blue Mold in Oranges by Damaging the Cell Membrane of Penicillium italicum and Enhancing Both Enzymatic and Non-Enzymatic Defense Mechanisms in Orange Fruits. Horticulturae. 2024; 10(10):1076. https://doi.org/10.3390/horticulturae10101076
Chicago/Turabian StyleEl-Nagar, Asmaa, Yasser S. A. Mazrou, Mansour M. El-Fawy, Mohamed K. Abou-Shlell, Mohamed A. A. Seleim, Abeer H. Makhlouf, and Mohamed G. A. Hegazy. 2024. "New Trichoderma Strains Suppress Blue Mold in Oranges by Damaging the Cell Membrane of Penicillium italicum and Enhancing Both Enzymatic and Non-Enzymatic Defense Mechanisms in Orange Fruits" Horticulturae 10, no. 10: 1076. https://doi.org/10.3390/horticulturae10101076
APA StyleEl-Nagar, A., Mazrou, Y. S. A., El-Fawy, M. M., Abou-Shlell, M. K., Seleim, M. A. A., Makhlouf, A. H., & Hegazy, M. G. A. (2024). New Trichoderma Strains Suppress Blue Mold in Oranges by Damaging the Cell Membrane of Penicillium italicum and Enhancing Both Enzymatic and Non-Enzymatic Defense Mechanisms in Orange Fruits. Horticulturae, 10(10), 1076. https://doi.org/10.3390/horticulturae10101076

